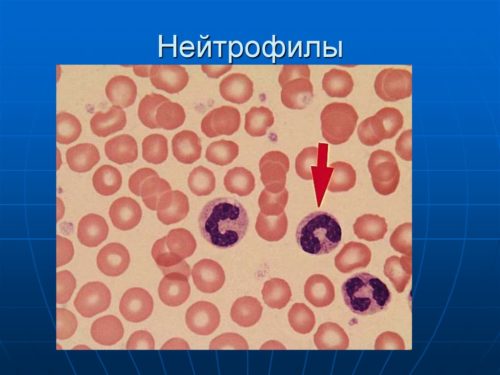

Для чего нужны нейтрофилы
Один нейтрофил может уничтожить до 25 бактериальных клеток. В норме защитные клетки через 6 часов мигрируют в печень, селезенку, где погибают, их сменяет новая порция клеток из костного мозга. Если она уничтожилась после поглощения бактерий, в кровь выделяются специальные вещества, которые усиливают синтезирование нейтрофилов в костном мозге, ускоряют выход в кровь незрелых нейтрофилов.
Данный процесс отражается на анализ крови – количество юных клеток увеличивается (лейкоцитарный сдвиг влево), что говорит о снижении нейтрофилов. После гибели защитной клетки в кровь выделяются ферменты, привлекающие другие лейкоцитарные клетки. Разрушенные нейтрофилы, патогенные возбудители образуют гной зеленоватого оттенка за счет наличия в нейтрофилах миелопероксидазы. Важно!
Нейтрофилы действуют преимущественно на бактерии, грибы, в отношении вирусных агентов их активность выражена слабо.
Нейтропения у детей представляет собой состояние, характеризующееся снижением уровня нейтрофилов в крови, что может привести к повышенной восприимчивости к инфекциям. Врачи отмечают, что причины этого состояния могут быть разнообразными: от наследственных заболеваний и аутоиммунных расстройств до воздействия лекарств и инфекций. Диагностика нейтропении включает общий анализ крови, а также дополнительные исследования для выявления первопричины. Лечение зависит от тяжести состояния и может варьироваться от наблюдения и коррекции рациона до назначения иммуномодуляторов или антибиотиков в случае инфекций. Важно, чтобы родители обращались к специалистам при первых признаках заболевания, чтобы минимизировать риски и обеспечить своевременную помощь.

Нейтропения у детей представляет собой состояние, характеризующееся снижением уровня нейтрофилов в крови, что может привести к повышенной восприимчивости к инфекциям. Врачи отмечают, что причины появления нейтропении могут быть разнообразными: от наследственных заболеваний и аутоиммунных расстройств до воздействия лекарств и инфекций. Диагностика включает общий анализ крови, который позволяет определить уровень нейтрофилов, а также дополнительные исследования для выявления первопричины. Лечение зависит от степени тяжести состояния и может варьироваться от наблюдения и поддерживающей терапии до применения иммуномодуляторов или антибиотиков в случае инфекций. Важно, чтобы родители обращались к специалистам при первых признаках заболевания, чтобы своевременно начать необходимую терапию и минимизировать риски для здоровья ребенка.
Показатели нормы
В лейкоцитарной формуле при анализе крови указывают 2 вида нейтрофилов: палочкоядерные (молодые), сегментоядерные (зрелая форма, которая преобладает над другими клетками). В анализе крови их количество указывают в процентах.
| Возраст | Палочкоядерные | Сегментоядерные |
| 1 сутки | 5-11 | 50-70 |
| 1-5 сутки | 1-6 | 34-55 |
| 5-10 сутки | 1-5 | 25-45 |
| 1 месяц | 1-5 | 18-30 |
| 1 год | 1-4 | 18-25 |
| 1-5 лет | 1-4 | 25-55 |
| 5-10 лет | 1-4 | 25-40 |
| старше 10 лет | 1-4 | 30-45 |
Снижение их количества называется нейтрофильной лейкопенией (нейтропения), повышение – нейтрофильным лейкоцитозом (нейтрофилия).
Причины, формы состояния

Причины снижения нейтрофилов:
- инфекционные болезни: грипп, ветряная оспа, корь, краснуха, гепатит, бруцеллез, брюшной тиф и другие;
- лечение антибактериальными, противовирусными препаратами;
- болезни крови: лейкоз, апластическая анемия и др.;
- химио-, радиотерапия;
- дефицит витамина В12, фолиевой кислоты;
- повышение уровня гормонов щитовидной железы;
- грибковые инфекции;
- опухоли.
В зависимости от уровня клеток в крови выделяют три степени тяжести: легкую, среднюю, тяжелую.
В основу классификации положен механизм развития состояния:
- Аутоиммунная нейтропения. Возникает при выработке антител против нейтрофилов. Процесс развивается при аутоиммунных заболеваниях либо выработка антител протекает изолированно.
- Лекарственная – на фоне приема препаратов, имеющих токсическое действие в отношении нейтрофилов: антибиотики (цефалоспорины, пенициллины), нейролептики, антиконвульсанты, противосудорожные. После химиотерапии угнетается синтезирование клеток в красном костном мозге, в том числе и нейтрофилов.
- Инфекционная. Связана с проникновением в организм инфекционных возбудителей.
- Врожденная – группа генетических болезней связанных со снижением уровня нейтрофилов.
- Фебрильная (нейтропеническая лихорадка) – опасное состояние, сопровождающееся высокой температурой, интоксикацией, быстрым распространением инфекции по организму. Чаще возникает на фоне приема цитостатиков по поводу онкологических заболеваний.
Также выделяют доброкачественную нейтропению у детей – хроническая форма состояния, которая не проявляется клиническими симптомами. Чаще связана с развитием костного мозга у детей до года.
Нейтропения детского возраста — это состояние, характеризующееся снижением уровня нейтрофилов в крови, что может повышать риск инфекций. Причины появления нейтропении могут быть разнообразными: от наследственных факторов и аутоиммунных заболеваний до воздействия лекарств и инфекций. Диагностика включает общий анализ крови, который позволяет определить уровень нейтрофилов, а также дополнительные исследования для выявления первопричины. Лечение зависит от причины и степени тяжести состояния. В некоторых случаях достаточно наблюдения, в других может потребоваться медикаментозная терапия или даже переливание крови. Важно, чтобы родители внимательно следили за состоянием ребенка и консультировались с врачом при любых признаках инфекций.

Нейтропения в детском возрасте — это состояние, характеризующееся снижением уровня нейтрофилов, что может привести к повышенной восприимчивости к инфекциям. Причины появления нейтропении могут быть разнообразными: от наследственных заболеваний и аутоиммунных расстройств до воздействия лекарств и инфекций. Диагностика включает общий анализ крови, который позволяет определить уровень нейтрофилов, а также дополнительные исследования для выявления первопричины. Лечение зависит от причины и может варьироваться от наблюдения и поддерживающей терапии до назначения медикаментов, таких как колониестимулирующие факторы, которые помогают увеличить выработку нейтрофилов. Важно, чтобы родители внимательно следили за состоянием ребенка и консультировались с врачом при появлении симптомов инфекций.
Симптомы
Проявление нейтропении зависит от степени снижения клеток. При легкой – симптомов не наблюдается. Выявляют ее случайно при лабораторном анализе по поводу заболеваний или на профилактическом обследовании. Незначительное отклонение показателя от нормы может быть связано с перенесенным бактериальным, вирусным заболеванием. При циклической нейтропении симптомов не наблюдается, показатель понижается или повышается на 8-10 дней, затем приходит в норму. При данных формах иммунная защита снижается, поэтому дети склонны к гриппу, ОРВИ.
При средней форме организм ослаблен, его устойчивость к грибковым, бактериальным, вирусным инфекциям снижается. У детей часто повышается температура, возникают воспалительные процессы в полости рта (стоматит, гингивит и др.). При отсутствии лечения, на фоне инфекций уровень нейтрофилов прогрессивно снижается (тяжелая форма).

- язвы во рту;
- пародонтоз;
- грибковые инфекции, поражающие кожу, внутренние органы;
- повышение температуры до 40°С;
- гнойные высыпания на коже;
- пневмония.
Распространение инфекции, подавление иммунных клеток ведет к заражению крови (сепсису), опасному состоянию, имеющему высокие показатели летальности. Важно!На выраженность симптомов влияет тип возбудителя, вид нейтропении, общее состояние иммунной системы.
Диагностика
Диагноз нейтропения ставят на основании результатов развернутого анализа крови. При легкой форме снижения клеток у ребенка 1-2 лет, анализ повторяют каждые 10-15 дней, чтобы поставить диагноз – доброкачественная нейтропения. Для определения сопутствующей патологии может потребоваться:
- рентгенография легких;
- УЗИ внутренних органов;
- анализ крови (маркеры) на выявление аутоиммунных, паразитарных, онкологических болезней.

Лечение нейтропении у детей
Выбор метода лечения зависит от вида снижения клеток. Педиатры, в том числе доктор Комаровский, при доброкачественной нейтропении детского возраста лечение не назначают –иммунная система еще формируется. Дети стоят на учете в поликлинике, сдают анализы каждые 3-4 месяца, чтобы выявить транзиторный характер состония При врожденном снижении клеток назначают гранулоцитарный колониестимулирующий фактор (Г-KCФ). Он стимулирует синтезирование, дифференцировку нейтрофилов в костном мозге. В зависимости от типа врожденной патологии его применяют курсами либо в течение всей жизни.
При тяжелых врожденных аномалиях пересаживают костный мозг. При развитии бактериальной инфекции показана антибиотикотерапия, иммуноглобулины, глюкокортикостероиды, дезинтоксикационная терапия. Если снижение клеток связано с анемией, дефицитом витаминов группы В показаны препараты железа, витамины, поливитаминные комплексы. При лекарственной нейтропении отменяют препараты, вызвавшие их снижение, через 1-2 недели повторно делают развернутый анализ крови.
Нейтрофилы – клетки иммунной системы, при их снижении у детей и взрослых повышается вероятность инфекционных, бактериальных инфекций. Изменение показателя у грудничков не считается патологией, лечение не назначают. Но контролировать показатели, состоять на учете у педиатра необходимо до стабилизации уровня всех подвидов лейкоцитарных клеток.
Вопрос-ответ
Что такое нейтропения и как она проявляется у детей?
Нейтропения — это состояние, характеризующееся снижением уровня нейтрофилов в крови, что делает ребенка более восприимчивым к инфекциям. У детей это может проявляться частыми простудами, инфекциями, повышенной температурой и усталостью. Важно следить за симптомами и обращаться к врачу при их появлении.
Какие основные причины нейтропении у детей?
Причины нейтропении могут быть разнообразными. Она может возникать из-за наследственных факторов, аутоиммунных заболеваний, инфекций, таких как вирусные инфекции, или в результате воздействия некоторых медикаментов. Также нейтропения может быть связана с нарушениями в костном мозге, где производятся клетки крови.
Как проводится диагностика нейтропении у детей?
Диагностика нейтропении включает общий анализ крови, который позволяет определить уровень нейтрофилов. Врач может также назначить дополнительные исследования, такие как анализ на наличие инфекций, биопсию костного мозга или генетические тесты, чтобы выяснить причину снижения уровня нейтрофилов и исключить другие заболевания.
Советы
СОВЕТ №1
Обратите внимание на симптомы. Если у вашего ребенка наблюдаются частые инфекции, усталость или необычные синяки, это может быть признаком нейтропении. Не откладывайте визит к врачу для диагностики.
СОВЕТ №2
Следите за рационом питания. Обеспечьте ребенка сбалансированным питанием, богатым витаминами и минералами, особенно витаминами группы B и C, которые могут поддерживать иммунную систему и способствовать производству белых кровяных клеток.
СОВЕТ №3
Регулярно проходите медицинские обследования. Если у вашего ребенка уже диагностирована нейтропения, важно регулярно проверять уровень нейтрофилов и следить за состоянием здоровья, чтобы вовремя выявить возможные осложнения.
СОВЕТ №4
Обсудите с врачом возможные варианты лечения. В зависимости от причины нейтропении, могут быть рекомендованы различные методы лечения, включая медикаментозную терапию или изменения в образе жизни. Не стесняйтесь задавать вопросы и уточнять все детали.

